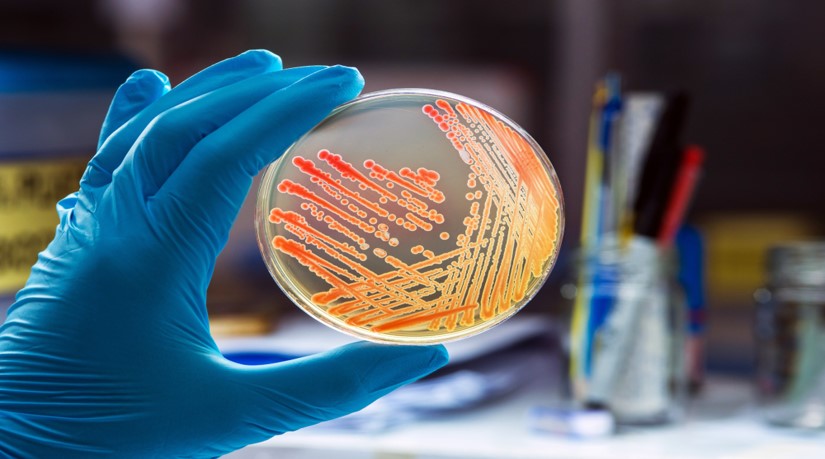

Do you need to complete bloodborne pathogens training? Learn the requirements of this certification in this guide to BPT.
Over the last 6 years, roughly 150 people have contracted HIV through occupational hazards. Add to that number of diseases people have contracted via other bloodborne pathogens and a very important truth comes to light…
Working with blood professionally presents serious risks.
In order to mitigate the risk that healthcare workers face when managing blood and similar bodily fluids, it’s required that at-risk people take what is known as bloodborne pathogen training.
Are you required to take bloodborne pathogens training? Are you curious to know what you need to learn/do in order to receive your certification?
Below, we outline paramount things quality training courses will cover and what you need to ensure that your certification is valid.
An Understanding of At-Risk Professions
One of the primary aspects of bloodborne pathogens training is an in-depth understanding of which professions are at risk and how. For example, a person in a lab that analyzes blood work could contract a disease differently than a nurse that actually draws blood.
Understanding the risks of each profession and how to circumvent them will help keep you and your co-workers safe.
You Must Learn Standard Precautions
One of the many tenants that you’ll learn during a qualified bloodborne pathogens training session is this:
You must treat all blood like it’s infected blood.
Even if you know for a fact that a patient’s blood is clean, you have to assume that the test(s) that led you to that conclusion were in some way flawed. You have to assume that contact with the blood you’re handling will lead you to contract a disease.
Once you’re operating under that premise, your training course should supply you with basic safety procedures that people across all blood handling professions can exercise to sharply reduce their odds of unsafe contact with blood.
Know What Safe and Non-safe Work Environments Look Like
OSHA outlines a variety of things that you should look out for in the work environment that will tip you off as to whether or not it’s safe. You can learn more about these signs online.
Safety basics include things needle disposal repositories. A quality sanitation staff. Also, employers should provide basic safety equipment to workers.
If you’re noticing that the safety standards outlined in your training are not being addressed in your workplace, you should file a complaint with OSHA immediately.
A single whistleblower could save lives.
Be Able to Identify and Use Protective Equipment
All of the protective equipment in the world is useless if you’re not sure how to properly utilize it to reduce your risk of contracting a disease.
In order to complete bloodborne pathogens training, you’ll need to be well versed in what encompasses safety equipment and how to properly leverage said equipment.
You may learn the use of equipment through digital training or via hands-on practice depending on the training your employer has opted into.
In our opinion, hands-on training when it comes to safety equipment use is preferable.
A Commitment to Retraining Annually
When you’re first hired into a profession that deals with blood, you’ll be required to do your pathogen training. What a lot of people don’t realize though is that training certifications must be renewed every year.
The reason for renewals is that new breakthroughs are arrived at when it comes to blood safety every year. Annual renewal ensures that employees are always kept in the loop when it comes to how they can better protect themselves.
Even if standards don’t change drastically from year to year, having your certification renewed serves as an excellent reminder regarding the dangers of bloodborne diseases. This will help you avoid complacency when doing your job.
Records of Training Dates, Sessions, Attendees and Job Titles
In order to prove that you’re certified to be able to work with blood, your employer will need to keep records regarding your training history.
Standards dictate that all training records include dates when training was conducted. What was covered in each session? Who attended those sessions and those attendee’s job titles?
If your employer is not keeping these records either on their own or through a third party training agency, contact your medical office’s broader governing body. You can also contact OSHA to ensure that records get kept going forward.
Assurance That Training Is Conducted By Reputable Agencies
Many healthcare facilities outsource their pathogen training to companies that specialize in conducting sessions. While outsourcing can be convenient, not all training programs get created equally.
Are you finding that the training you’re receiving seems rushed or lackluster? It could be that the agency you’re working with is not properly accredited to give bloodborne pathogens training. Any training you receive from the unqualified agency may not count towards you receiving a legal certification.
As always, OSHA is a great resource if you’re concerned that your training is not meeting legal requirements. You can also voice your concerns directly to your employer.
Wrapping Up Bloodborne Pathogens Training Requirements
We’ve just outlined for you a number of things that you should expect to learn through a qualified bloodborne pathogens training program. We’ve also disclosed how records should be kept and what you should do to ensure that the training you undergo is recognized.
We hope that our information has added some clarity to your training concerns. We welcome you to browse more of our healthcare content if you have additional questions.
As we mentioned, OSHA and your employer can also be excellent resources.



